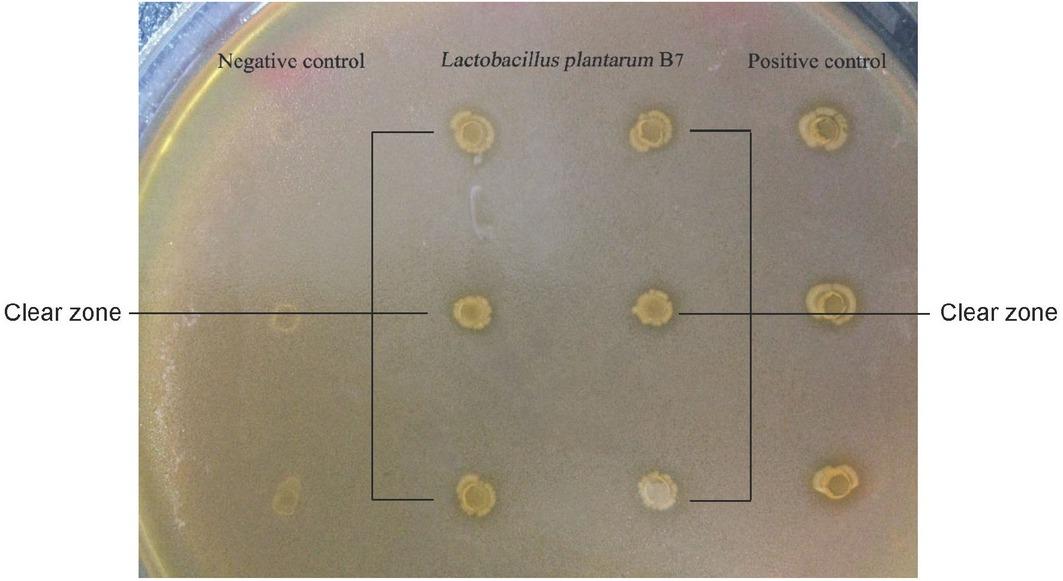

Figure 1

Figure 2

Figure 3

Figure 4

Figure 5

Figure 6

Figure 7

© 2019 Siwaporn Wongsen, Duangporn Werawatganon, Somying Tumwasorn, published by Chulalongkorn University
This work is licensed under the Creative Commons Attribution-NonCommercial-NoDerivatives 4.0 License.